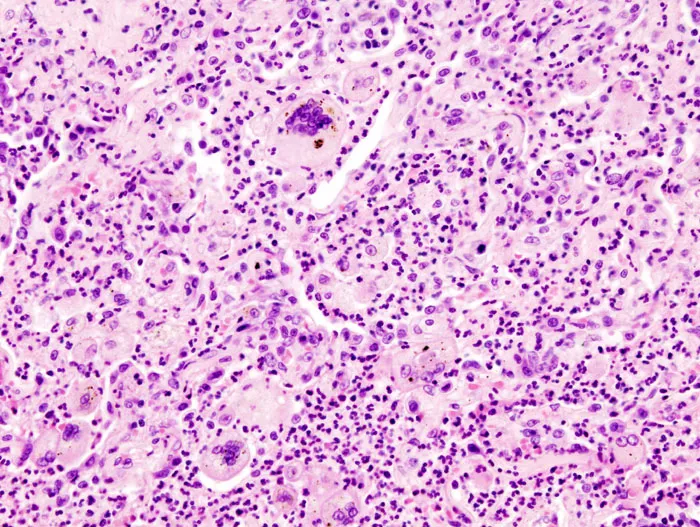
Histological comparison of different granuloma types

Enter your email to get your 85% OFF code and unlock the full USMLE question bank on the app.
Every disease begins with cellular disruption, and understanding how cells respond to injury, die, and trigger inflammation forms the foundation of all clinical reasoning. You'll master the molecular mechanisms behind apoptosis and necrosis, decode the inflammatory cascade that orchestrates healing or harm, and learn to recognize pathological patterns that guide diagnosis across organ systems. By integrating cellular events with multi-system disease processes, you'll build the diagnostic and therapeutic framework essential for clinical decision-making in any specialty.

| Injury Type | Reversibility | Timeline | Key Features | Clinical Examples |
|---|---|---|---|---|
| Hydropic | Reversible | Minutes-Hours | Swelling, ↑Na+/K+ pump failure | Ischemia, hypoxia |
| Fatty Change | Reversible | Hours-Days | Lipid accumulation, ↓β-oxidation | Alcohol, diabetes |
| Coagulative | Irreversible | 6-24 hours | Protein denaturation, architecture preserved | MI, stroke |
| Liquefactive | Irreversible | 24-72 hours | Enzymatic digestion, cavity formation | Brain infarct, abscess |
| Caseous | Irreversible | Days-Weeks | Cheese-like, granulomatous | TB, fungal infections |
ATP Depletion Cascade
Free Radical Injury
⭐ Clinical Pearl: 85% of reperfusion injury results from free radical generation, not the initial ischemia itself
💡 Master This: ATP depletion → Na+/K+ pump failure → Ca2+ influx → enzyme activation → irreversible damage. This sequence explains why early reperfusion (within 6 hours) prevents progression from reversible to irreversible injury.
📌 Remember: CAFE - Calcium ATP Free radicals Enzymes - the four horsemen of cellular death
Understanding these injury mechanisms provides the foundation for recognizing how cellular stress patterns manifest as tissue-level pathological changes, setting the stage for mastering inflammation and repair responses.
| Feature | Apoptosis | Necrosis | Clinical Significance |
|---|---|---|---|
| Energy | ATP-dependent | ATP-independent | Determines reversibility window |
| Membrane | Intact, phosphatidylserine flip | Disrupted, permeable | Inflammatory response trigger |
| DNA | Ladder pattern (180bp) | Random fragmentation | Diagnostic gel electrophoresis |
| Inflammation | Minimal (silent death) | Intense (danger signals) | Treatment strategy selection |
| Reversibility | Committed at caspase-3 | Variable until membrane loss | Therapeutic intervention timing |
Intrinsic Pathway (Mitochondrial)
Extrinsic Pathway (Death Receptor)

⭐ Clinical Pearl: Bcl-2/Bax ratio >2 predicts chemotherapy resistance in 75% of lymphomas, as cells cannot execute apoptosis despite DNA damage
Coagulative Necrosis
Liquefactive Necrosis
💡 Master This: Coagulative necrosis preserves tissue architecture because protein denaturation blocks enzymatic digestion, while liquefactive necrosis occurs where high enzyme concentrations (brain, neutrophils) overwhelm structural proteins.
⭐ Clinical Pearl: Caspase-3 immunostaining distinguishes apoptosis from necrosis in >95% of cases, crucial for determining whether cell death resulted from programmed elimination or pathological injury.
This death pathway mastery enables recognition of tissue injury patterns and guides therapeutic interventions targeting specific cellular death mechanisms.
| Phase | Duration | Key Players | Molecular Signals | Clinical Manifestations |
|---|---|---|---|---|
| Initiation | 0-30 minutes | Mast cells, complement | Histamine, C3a, C5a | Vasodilation, ↑permeability |
| Amplification | 30min-6hrs | Neutrophils, platelets | IL-1β, TNF-α, LTB4 | Pain, swelling, heat |
| Resolution | 6-48 hours | Macrophages, eosinophils | IL-10, TGF-β, lipoxins | Tissue repair initiation |
| Chronic | >48 hours | Lymphocytes, plasma cells | IFN-γ, IL-17, IL-4 | Fibrosis, granuloma formation |
Vasodilation Cascade
Permeability Changes

⭐ Clinical Pearl: Starling forces reverse during inflammation - hydrostatic pressure (35 mmHg) plus ↓oncotic pressure (15 mmHg) drives massive fluid extravasation
Neutrophil Mobilization
Monocyte-Macrophage Transition
📌 Remember: SMART neutrophils - Selectin rolling Margination Adhesion Rolling Transmigration
💡 Master This: The selectin-integrin cascade enables neutrophils to decelerate from 1000 μm/sec (blood flow) to <10 μm/sec (tissue migration) through sequential molecular braking systems.
⭐ Clinical Pearl: C-reactive protein rises 100-1000 fold within 6-12 hours, making it the most sensitive acute-phase reactant for detecting inflammation severity.
This inflammatory orchestration framework reveals how molecular timing determines whether inflammation resolves appropriately or progresses to chronic tissue damage.

| Pattern | Key Features | Timeline | Associated Conditions | Diagnostic Accuracy |
|---|---|---|---|---|
| Acute Inflammation | Neutrophil infiltrate, edema | Hours-days | Infection, trauma, ischemia | >95% specificity |
| Chronic Inflammation | Lymphocytes, plasma cells, fibrosis | Weeks-months | Autoimmune, persistent infection | 85-90% sensitivity |
| Granulomatous | Epithelioid cells, giant cells | Weeks-years | TB, sarcoidosis, foreign body | 90-95% specificity |
| Neoplastic | Cellular atypia, mitoses, invasion | Variable | Benign vs malignant tumors | 98% with immunostains |
| Degenerative | Cell loss, fibrosis, calcification | Months-years | Aging, chronic disease | 80-85% correlation |
Acute vs Chronic Inflammation
Granulomatous Recognition
⭐ Clinical Pearl: Langhans giant cells with peripheral nuclei suggest infectious granulomas in 80% of cases, while foreign body giant cells with random nuclei indicate non-infectious causes
Benign vs Malignant Criteria
Grading Systems

💡 Master This: The "Rule of Thirds" - Grade 1 tumors have >75% normal architecture, Grade 2 have 25-75%, and Grade 3 have <25% recognizable tissue patterns.
⭐ Clinical Pearl: Ki-67 proliferation index >20% correlates with aggressive behavior in 85% of solid tumors, regardless of histological grade.
This pattern recognition mastery transforms microscopic observations into precise diagnostic conclusions, enabling accurate disease classification and treatment planning.
| Condition Severity | First-Line Therapy | Success Rate | Escalation Trigger | Alternative Options |
|---|---|---|---|---|
| Mild-Moderate | Conservative management | 70-85% | No improvement in 2-4 weeks | Pharmacological intervention |
| Moderate-Severe | Standard pharmacotherapy | 60-80% | <50% symptom reduction | Combination therapy |
| Severe | Intensive treatment | 40-70% | Treatment failure in 48-72hrs | Experimental protocols |
| Critical | Emergency intervention | 20-60% | Immediate deterioration | Palliative care consideration |
| Refractory | Salvage therapy | 10-40% | Multiple treatment failures | Clinical trial enrollment |
Acute Inflammation Management
Chronic Inflammation Protocols
⭐ Clinical Pearl: Early aggressive therapy within 3-6 months of symptom onset improves long-term outcomes by 40-60% in autoimmune conditions
Empirical Therapy Selection
Resistance Pattern Adaptation
💡 Master This: Antibiotic stewardship requires balancing empirical coverage (broad enough to treat likely pathogens) with resistance prevention (narrow enough to minimize ecological pressure).
⭐ Clinical Pearl: Procalcitonin-guided therapy reduces antibiotic duration by 25-30% without compromising clinical outcomes in respiratory tract infections.
These therapeutic algorithms provide systematic frameworks for translating pathological understanding into evidence-based treatment decisions across diverse clinical scenarios.
| Primary System | Secondary Effects | Timeline | Molecular Mediators | Clinical Manifestations |
|---|---|---|---|---|
| Cardiovascular | Renal, hepatic, pulmonary | Hours-days | ANP, BNP, aldosterone | CHF, edema, dyspnea |
| Renal | Cardiovascular, bone, hematologic | Days-weeks | EPO, PTH, phosphate | Anemia, bone disease, HTN |
| Hepatic | Coagulation, metabolic, neurologic | Hours-weeks | Albumin, clotting factors | Bleeding, encephalopathy |
| Immune | All systems | Minutes-hours | Cytokines, complement | SIRS, organ dysfunction |
| Endocrine | Metabolic, cardiovascular | Hours-months | Hormones, glucose | DM complications, atherosclerosis |
Systemic Inflammatory Response (SIRS)
Metabolic Integration
⭐ Clinical Pearl: SOFA score >2 indicates organ dysfunction, with each point increase associated with 15-20% mortality increase
Cardiorenal Syndrome
Renal-Bone-Mineral Axis
💡 Master This: The "kidney-heart axis" demonstrates how hemodynamic (forward flow), neurohormonal (RAAS), and venous congestion (backward pressure) mechanisms create bidirectional organ dysfunction.
⭐ Clinical Pearl: Albumin >1.5g/kg plus vasoconstrictors improve hepatorenal syndrome survival by 40-60%, demonstrating how volume expansion plus systemic vasoconstriction can reverse functional renal failure.
This multi-system integration framework reveals how understanding cross-organ communication enables prediction and management of complex pathological cascades that define critical illness.
| Parameter | Normal Range | Mild Abnormal | Moderate Abnormal | Severe Abnormal | Critical Action |
|---|---|---|---|---|---|
| CRP | <3 mg/L | 3-10 mg/L | 10-100 mg/L | >100 mg/L | Sepsis workup |
| Troponin | <0.04 ng/mL | 0.04-0.1 ng/mL | 0.1-1.0 ng/mL | >1.0 ng/mL | STEMI protocol |
| Creatinine | 0.6-1.2 mg/dL | 1.3-1.9 mg/dL | 2.0-3.9 mg/dL | >4.0 mg/dL | Dialysis consideration |
| Bilirubin | <1.2 mg/dL | 1.3-2.5 mg/dL | 2.6-10 mg/dL | >10 mg/dL | Liver failure workup |
| Lactate | <2 mmol/L | 2-4 mmol/L | 4-8 mmol/L | >8 mmol/L | Shock protocol |
Inflammation Severity Scale
Tissue Injury Markers
⭐ Clinical Pearl: "Rule of 3s" - Troponin peaks at 3-6 hours, ALT peaks at 3 days, Creatinine peaks at 3-7 days after acute injury
💡 Master This: Time-sensitive pathology follows the "Golden Hour" principle - early intervention within critical time windows reduces morbidity by 50-80% across most emergency conditions.
⭐ Clinical Pearl: Early warning scores (NEWS, MEWS) with thresholds >5 predict clinical deterioration with 85-90% sensitivity, enabling proactive intervention before organ failure.
📌 Remember: SMART monitoring - Specific parameters Measured At Regular intervals with Thresholds for action
This clinical mastery arsenal transforms pathological knowledge into practical tools for rapid assessment, accurate diagnosis, and evidence-based treatment across diverse clinical scenarios.
Signup to continue reading this lesson and unlimited access questions, flashcards, AI notes, and more
Have doubts about this lesson?
Ask Rezzy, your AI Study Mate, to explain anything you didn't understand
Get full Oncourse access with lessons, practice questions, flashcards and AI study tools.
Scan to download app